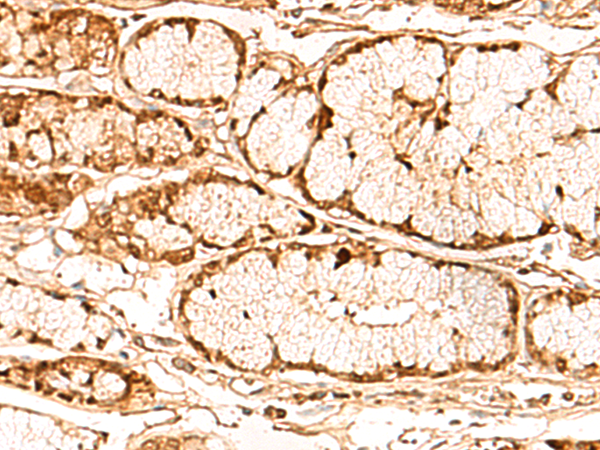

中文名稱: 兔抗PRKAG2多克隆抗體
英文名稱: Anti-PRKAG2 rabbit polyclonal antibody
別 名: protein kinase AMP-activated non-catalytic subunit gamma 2; AAKG; CMH6; WPWS; AAKG2; H91620p
相關(guān)類別: 一抗
儲 存: 冷凍(-20℃)
宿 主: Rabbit
抗 原: PRKAG2
反應(yīng)種屬: Human, Mouse
標(biāo) 記 物: Unconjugate
克隆類型: rabbit polyclonal
技術(shù)規(guī)格
|
Background: |
AMP-activated protein kinase (AMPK) is a heterotrimeric protein composed of a catalytic alpha subunit, a noncatalytic beta subunit, and a noncatalytic regulatory gamma subunit. Various forms of each of these subunits exist, encoded by different genes. AMPK is an important energy-sensing enzyme that monitors cellular energy status and functions by inactivating key enzymes involved in regulating de novo biosynthesis of fatty acid and cholesterol. This gene is a member of the AMPK gamma subunit family. Mutations in this gene have been associated with Wolff-Parkinson-White syndrome, familial hypertrophic cardiomyopathy, and glycogen storage disease of the heart. Alternate transcriptional splice variants, encoding different isoforms, have been characterized. |
|
Applications: |
ELISA, WB, IHC |
|
Name of antibody: |
PRKAG2 |
|
Immunogen: |
Fusion protein of human PRKAG2 |
|
Full name: |
protein kinase AMP-activated non-catalytic subunit gamma 2 |
|
Synonyms: |
AAKG; CMH6; WPWS; AAKG2; H91620p |
|
SwissProt: |
Q9UGJ0 |
|
ELISA Recommended dilution: |
5000-10000 |
|
IHC positive control: |
Human gastric cancer |
|
IHC Recommend dilution: |
50-300 |
|
WB Predicted band size: |
63 kDa |
|
WB Positive control: |
Mouse heart tissue lysate |
|
WB Recommended dilution: |
200-1000 |

購物車
幫助
021-54845833/15800441009
